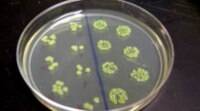

来源: 时间:2022-06-21 17:35:16
为了研究微重力对细菌抗生素耐药性的影响,科学家们准备将大肠杆菌 (一种与尿路感染和食源性疾病有关的常见细菌病原体) 送往国际空间站 (ISS)。据Space.com报道,大肠杆菌抗菌卫星 (EcAMSat) 任务定于周六在ATK的Cygnus货运飞船上向国际空间站发射,并为Expedition 53机组人员提供了一系列其他科学实验和补给品。
美国国家航空航天局说,抗生素耐药性可能对宇航员构成危险,尤其是因为微重力已被证明会削弱人类的免疫反应。大肠杆菌抗菌卫星任务将研究航天对细菌抗生素耐药性的影响及其遗传基础。该实验将使两种大肠杆菌菌株 (一种具有抗性基因,另一种没有抗性基因) 暴露于三种不同剂量的抗生素中,然后检查每组的生存能力。
NASA说: “这项调查的结果可能有助于确定适当的抗生素剂量,以保护长期人类太空飞行期间的宇航员健康,并帮助我们了解抗生素有效性如何随着地球压力的变化而变化。”该实验将在6U cubesat中进行,而不是被安置在空间站内,这是一颗小型卫星,其体积是单个cubesat的六倍。
实验方案的基本方案将在EcAMSat卫星发射后四天开始,方法是允许48个微流体孔中包含的大肠杆菌细菌的初始生长和饥饿期。这项研究旨在确定 “抑制大肠杆菌 (大肠杆菌) 生长所需的最低剂量的抗生素,大肠杆菌是一种导致人类和动物感染的细菌病原体,” NASA官员在对实验的描述中写道。
相关推荐
猜你喜欢